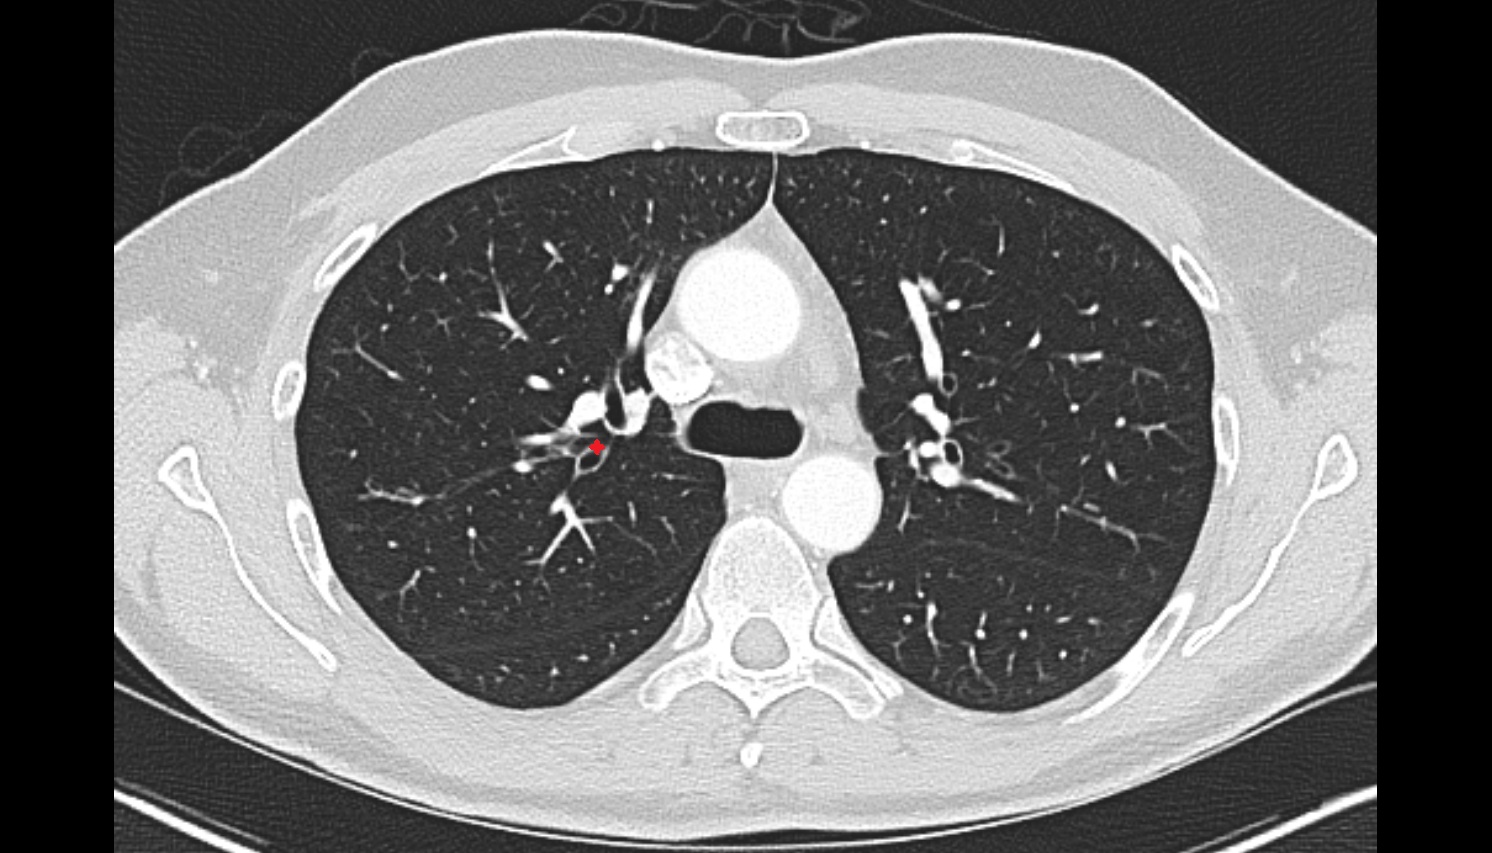
Posterior segmental bronchus of right lung  CT axial image -img-00000-00000

Topic
- Anterior cerebral artery
- Anterior Choroidal Artery
- Anterior Communicating Artery
- Anterior temporal artery anatomy
- Anterolateral central (lenticulostriate) arteries anatomy
- Anteromedial central (perforating) arteries anatomy
- Artery of central sulcus
- Artery of postcentral sulcus
- Artery of precentral sulcus
- Artery to angular gyrus anatomy
- Basilar artery
- Callosomarginal artery
- Inferior hypophyseal artery anatomy
- Internal carotid artery
- Labyrinthine artery
- Lateral frontobasal artery
- Long medial striate artery
- Medial frontobasal artery
- Middle cerebral artery
- Middle temporal artery
- Ophthalmic artery
- Paracentral artery
- Pericallosal artery
- Polar frontal artery
- Polar temporal artery
- Pontine arteries
- Posterior cerebral artery
- Posterior communicating artery
- Posterior lateral choroidal artery
- Posterior parietal artery
- Posteromedial central (perforating) arteries
- Precuneal artery
- Superior cerebellar artery
- Superior hypophyseal artery
- Anterior lobe of cerebellum
- Anterior quadrangular lobule
- Arbor Vitae (Cerebellar White Matter)
- Central lobule
- Cerebellar commissure
- Cerebellar tentorium
- Cerebellopontine angle
- Cerebellum
- Culmen
- Declive
- Dentate nucleus
- Flocculonodular lobe
- Folium of Vermis
- Horizontal fissure (cerebellum)
- Inferior cerebellar peduncle
- Inferior semilunar lobule
- Intraculminate fissure
- Lingula of cerebellum
- Lunogracle fissure
- Middle cerebellar peduncle
- Nodule of vermis
- Paramedian lobule
- Posterior lobe of cerebellum
- Posterior superior fissure
- Posterolateral fissure
- Prebiventral fissure
- Precentral fissure
- Preculminate fissure
- Primary fissure
- Pyramis of vermis
- Secondary fissure
- Simple lobule
- Superior medullary velum
- Superior semilunar lobule of cerebellum
- Tonsil of cerebellum
- Tuber of vermis
- Uvula of vermis
- Wing of central lobule
- Ambient cistern
- Carotid cistern
- Chiasmatic cistern
- Cistern of central sulcus
- Cistern of lamina terminalis
- Cistern of lateral cerebral fossa
- Cistern of transverse fissure
- Crural cistern
- Interpeduncular Cistern
- Lateral cerebellomedullary cistern
- Oculomotor cistern
- Olfactory cistern
- Pericallosal cistern
- Pontocerebellar cistern
- Posterior cerebellomedullary cistern (cisterna magna)
- Prepontine cistern
- Quadrigeminal cistern
- Superior cerebellar cistern
- Abducens nerve (Cranial nerve VI)
- Accessory Nerve (Cranial nerve XI)
- Cochlea
- Cochlear nerve (Cranial nerve VIII)
- Facial Nerve (Cranial nerve VII)
- Glossopharyngeal nerve (Cranial nerve IX)
- Hypoglossal Nerve (Cranial nerve XII)
- Inferior branch vestibular nerve
- Inferior salivatory nucleus
- Inferior vestibular nucleus
- Lacrimal nucleus
- Lateral vestibular nucleus
- Medial vestibular nucleus
- Mesencephalic nucleus of trigeminal nerve
- Motor nucleus of facial nerve
- Motor nucleus of trigeminal nerve
- Nucleus of abducens nerve
- Nucleus of hypoglossal nerve
- Nucleus of oculomotor nerve
- Nucleus of solitary tract
- Nucleus of trochlear nerve
- Oculomotor Nerve (Cranial Nerve III)
- Olfactory bulb
- Olfactory Nerve (Cranial Nerve I)
- Olfactory tract
- Optic chiasm
- Optic Nerve (Cranial Nerve II)
- Posterior cochlear nucleus
- Principal sensory nucleus of the trigeminal nerve
- Semicircular Canals
- Spinal nucleus of trigeminal nerve
- Superior branch of vestibular nerve
- Superior salivatory nucleus
- Superior vestibular nucleus
- Trigeminal ganglion
- Trigeminal nerve (Cranial nerve V)
- Trochlear nerve (Cranial nerve IV)
- Vagus nerve (Cranial nerve X)
- Vestibular ganglion
- Vestibule
- Vestibulocochlear nerve (Cranial nerve VIII)
- Anterior cochlear nucleus
- Angular gyrus
- Anterior long insular gyrus
- Anterior orbital gyrus
- Anterior short insular gyrus
- Cingulate gyrus
- Cuneus
- Descending occipital gyrus
- Frontal operculum
- Frontal pole
- Inferior frontal gyrus
- Inferior occipital gyrus
- Inferior temporal gyrus
- Insular cortex
- Lateral occipitotemporal gyrus
- Lateral orbital gyrus
- Lingual gyrus
- Long gyri of insula
- Medial frontal gyrus
- Medial occipitotemporal gyrus
- Medial orbital gyrus
- Middle frontal gyrus
- Middle occipital gyrus
- Middle short insular gyrus
- Middle temporal gyrus
- Occipital pole
- Parahippocampal gyrus
- Paraterminal gyrus
- Pars opercularis of inferior frontal gyrus
- Pars orbitalis of inferior frontal gyrus
- Pars triangularis of inferior frontal gyrus
- Postcentral gyrus
- Posterior long insular gyrus
- Posterior orbital gyrus
- Posterior short insular gyrus
- Precentral gyrus
- Precuneus
- Short gyri of insula
- Straight gyrus
- Superior frontal gyrus
- Superior occipital gyrus
- Superior parietal lobule
- Superior temporal gyrus
- Supramarginal gyrus
- Temporal pole
- Transverse temporal gyri
- Alveus
- Amygdala
- Choroid plexus of lateral ventricle
- Cornu Ammonis 1 (CA1)
- Cornu ammonis 2 (CA2)
- Cornu ammonis 3 (CA3)
- Cornu ammonis 4 (CA4)
- Cornu ammonis
- Dentate gyrus
- Fimbria of hippocampus
- Hippocampal body
- Hippocampal head
- Hippocampal tail
- Parasubiculum (Presubiculum)
- Posterior medial choroidal artery
- Prosubiculum
- Subiculum
- Uncus
- Vestigial hippocampal sulcus
- Aqueduct of midbrain (Sylvian Aqueduct)
- Brachium of inferior colliculus
- Brachium of superior colliculus
- Cerebral crus
- Decussation of the superior cerebellar peduncles
- Inferior colliculus
- Inferior olive
- Lateral longitudinal fasciculus
- Medial longitudinal fasciculus
- Medulla oblongata
- Pons
- Pontine nucleus
- Pyramids of the medulla oblongata
- Red nucleus
- Substantia nigra
- Superior colliculus
- Tegmentum of midbrain
- Anterior commissure
- Anterior intercavernous sinus
- Anterior limb of internal capsule
- Anterior lobe of pituitary gland
- Body of caudate nucleus
- Body of corpus callosum
- Body of fornix
- Calcarine spur
- Caudato-lenticular bridges
- Cave of septum pellucidum
- Central canal
- Choroid plexus of fourth ventricle
- Claustrum
- Column of fornix
- Corona radiata
- Corticospinal tract
- Crus of fornix
- External capsule
- Foramen caecum of medulla oblongata
- Frenulum veli
- Genu of corpus callosum
- genu of internal capsule
- Globus pallidus external segment
- Globus pallidus internal segment
- Habenular commissure
- Head of caudate nucleus
- Inferior opening of cerebral aqueduct
- Insular threshold
- Internal medullary lamina
- Interpeduncular fossa
- Interthalamic adhesion
- Isthmus of cingulate gyrus
- Lamina terminalis
- Lateral geniculate body
- Limbic lobe
- Mammillary body
- Medial geniculate body
- Optic tract
- Pineal recess
- Pituitary gland
- Pituitary stalk
- Posterior commissure
- Posterior intercavernous sinus
- Posterior limb of internal capsule
- Posterior lobe pituitary gland
- Preoptic area
- Pulvinar
- Putamen
- Raphe of pons
- Rostrum of corpus callosum
- Septum pellucidum
- Upper cervical spinal cord
- Splenium of corpus callosum
- Superior opening of the cerebral aqueduct
- Suprapineal recess
- Tail of caudate nucleus
- Thalamus
- Transverse pontine fiber
- Trigeminal cave
- Tuber cinereum
- Anterior ascending ramus of Sylvian fissure
- Anterior horizontal ramus of Sylvian fissure
- Anterior median fissure of medulla oblongata
- Basilar sulcus
- Calcarine Sulcus
- Central sulcus
- Central sulcus of insula
- Cingulate sulcus
- Circular sulcus of insula
- Collateral sulcus
- Hippocampal sulcus
- Inferior frontal sulcus
- Inferior temporal sulcus
- Intraparietal sulcus
- Lateral sulcus (Sylvian fissure)
- Longitudinal cerebral fissure
- Marginal sulcus
- Median sulcus of the 4th ventricle
- Occipitotemporal sulcus
- Olfactory sulcus
- Para-brachial recess
- Paracentral sulcus
- Parietooccipital sulcus
- Pontomedullary sulcus
- Postcentral sulcus
- Posterior ramus of lateral sulcus
- Post-olivary sulcus
- Precentral sulcus
- Pre-olivary sulcus
- Rhinal sulcus
- Subparietal sulcus
- Sulcus of corpus callosum
- Superior frontal sulcus
- Superior temporal sulcus
- Ventrolateral sulcus of medulla oblongata
- Anterior cerebral veins
- Anterior vein of caudate nucleus
- Anterolateral medullary vein
- Anteromedian medullary vein
- Anteromedian pontine vein
- Basal vein of rosenthal
- Basilar plexus
- cavernous sinus
- Confluence of sinuses
- Deep mddle cerebral veins
- Diploic veins
- Dorsal vein of corpus callosum
- Frontal veins
- Frontopolar vein
- Great cerebral vein
- Inferior anastomotic vein (Vein of Labbé)
- Inferior hemispheric veins of the cerebellum
- Inferior petrosal sinus
- Inferior sagittal sinus
- Inferior vein of vermis
- Internal cerebral vein
- Internal jugular vein
- interpeduncular veins
- Lateral mesencephalic vein
- Lateral pontine vein
- Lateral vein of lateral ventricle
- Marginal sinus
- Mastoid emissary vein
- Occipital emissary vein
- Occipital sinus
- Occipital veins
- Parietal veins
- Petrosal vein
- Posterior mesencephalic vein
- Posterior vein of caudate nucleus
- Posterior veins of septum pellucidum
- Posteromedian medullary vein
- Precentral cerebellar vein
- Sigmoid sinus
- Straight sinus
- Superficial cerebral veins
- Superficial middle cerebral vein
- Superior anastomotic vein
- Superior cerebellar vein
- Superior hemispheric veins of the cerebellum
- Superior petrosal sinus
- Superior sagittal sinus
- Superior thalamic veins
- Superior thalamostriate vein
- Superior vein of vermis
- Transverse sinus
- Transverse veins of caudate nucleus
- Vein of lateral recess of fourth ventricle
- Vein of septum pellucidum
- Venous plexus of foramen ovale
- Venous plexus of hypoglossal canal
- Atrium of lateral ventricle
- Central part of lateral ventricle
- Fourth ventricle
- Frontal horn of lateral ventricle
- Infundibular recess
- Interventricular foramen
- Lateral aperture of the fourth ventricle
- Lateral recess fourth ventricle
- Median aperture of the fourth ventricle
- Obex
- Occipital horn of lateral ventricle
- Supraoptic recess
- Temporal horn of lateral ventricle
- Third ventricle
- Anterior Band of Articular Disc TMJ
- Posterior band of articular disc, TMJ
- Articular capsule of temporomandibular joint
- Articular disc of temporomandibular joint
- Articular eminence
- Articular surface of mandibular fossa
- Articular tubercle
- Attachment of inferior head of lateral pterygoid muscle
- Attachment of superior head of lateral pterygoid muscle
- Auricle (Pinna)
- External acoustic meatus
- Glenoid process of parotid gland
- Intermediate zone of articular disc
- Lateral temporomandibular ligament
- Parotid gland
- Superior retrodiscal layer
- Superior synovial membrane of temporomandibular joint
- Temporomandibular joint
- Mandible
- Mandibular condyle
- Mandibular fossa
- Mastoid process
- Neck of mandible
- Petrous part of temporal bone
- Ramus of mandible
- Sheath of styloid process
- Squamous part of temporal bone
- Styloid process
- Tympanic part of temporal bone
- Zygomatic process of temporal bone
- Deep part of masseter muscle
- Superficial part of masseter
- Superior head of lateral pterygoid muscle
- Inferior head of lateral pterygoid muscle
- Lateral pterygoid muscle
- Masseter muscle
- Medial pterygoid muscle
- Temporalis muscle
- Auriculotemporal nerve
- Maxillary veins
- Transverse facial vein
- Transverse facial artery
- Pterygoid venous plexus
- Tragus of ear
- Crus helix of ear
- Superficial temporal vein
- Posterior auricular vein
- Retromandibular vein
- Superficial temporal artery
- Oculomotor nerve (Superior branch)
- Oculomotor nerve (inferior branch)
- Abducens nerve (orbital part )
- Maxillary nerve
- Intracranial part of optic nerve
- Frontal nerve
- Superior rectus muscle
- Superior ophthalmic vein
- Lacrimal artery
- Lateral rectus muscle
- Inferior ophthalmic vein
- Zygomatic nerve
- Levator palpebrae superioris muscle
- Superior oblique muscle
- Medial rectus muscle
- Orbital part of optic nerve
- Retrobulbar fat
- Inferior rectus muscle
- Infraorbital nerve
- Optic nerve sheath
- Subarachnoid space of optic nerve
- Common tendinous ring (Annulus of zinn)
- Optic canal
- Superior eyelid
- Inferior eyelid
- Superior tarsus
- Inferior tarsus
- Inferior oblique muscle
- Orbicularis oculi muscle
- Lacrimal gland
- Lacrimal nerve
- Lacrimal vein
- Lacrimal canaliculi
- lens of the eye
- Cornea
- Iris
- Pupil
- Anterior chamber of eyeball
- Posterior chamber of eyeball
- Vitreous chamber of eyeball
- Sclera
- Choroid
- Retina
- Nasolacrimal duct (Tear duct)
- Supratrochlear vein
- Supratrochlear nerve
- Supratrochlear artery
- Supraorbital nerve
- Supraorbital artery
- Supraorbital vein
- Optic disc
- Nasofrontal vein
- Whitnall's ligament
- Lockwood’s ligament
- Lateral canthal ligament
- Medial canthal ligament
- Brachiocephalic trunk
- Carotid bifurcation
- Common carotid artery
- External carotid artery
- Facial artery
- Inferior thyroid artery
- Internal carotid artery (cavernous part)
- Internal carotid artery (cervical part)
- Internal carotid artery (petrous part)
- Subclavian artery
- Left subclavian artery
- Right subclavian artery
- Lingual artery
- Maxillary artery
- Posterior auricular artery
- Transverse cervical artery
- Anterior jugular vein
- External jugular vein
- Facial vein
- Submental vein
- Superior bulb of internal jugular vein
- Cervical spinal nerve 1 (C1)
- Cervical spinal nerve 2 (C2)
- Cervical spinal nerve 3 (C3)
- Cervical spinal nerve 4 (C4)
- Cervical spinal nerve 5 (C5)
- Cervical spinal nerve 6 (C6)
- Cervical spinal nerve 7 (C7)
- Cervical spinal nerve 8 (C8)
- Mandibular canal
- inferior alveolar artery
- Inferior alveolar nerve
- Mental nerve
- Auricularis anterior muscle
- Auricularis posterior muscle
- Buccinator muscle
- Depressor anguli oris muscle
- Depressor labii inferioris muscle
- Depressor septi nasi muscle
- Hyoglossus muscle
- Cricothyroid muscle
- Hyoglossus
- Iliocostalis cervicis muscle
- Inferior belly of omohyoid muscle
- Inferior longitudinal lingual muscle
- Lateral cricoarytenoid muscle
- Levator anguli oris muscle
- Levator labii superioris alaeque nasi muscle
- Levator labii superioris muscle
- Superior longitudinal muscle of tongue
- Inferior longitudinal muscle of tongue
- Transverse muscle of the tongue
- Longissimus capitis muscle
- Longissimus cervicis muscle
- Longus capitis muscle
- Longus colli muscle
- Masseter muscle (Deep part)
- Masseter muscle (Superficial part)
- Superficial head of medial pterygoid muscle
- Mentalis muscle
- Middle constrictor muscle of pharynx
- Multifidus muscles
- Mylohyoid muscle
- Nasalis muscle
- Obliquus inferior capitis muscle
- Obliquus superior capitis muscle
- Orbicularis oculi muscle (Orbital part)
- Orbicularis oculi muscle (Preseptal part)
- Orbicularis oris muscle
- Palatoglossus muscle
- Palatopharyngeus muscle
- Pectoralis major muscle
- Platysma muscle
- Posterior belly of digastric muscle
- Anterior belly of digastric muscle
- Posterior cricoarytenoid muscle
- Rectus capitis anterior muscle
- Rectus capitis lateralis muscle
- Rectus capitis posterior major muscle
- Rectus capitis posterior minor muscle
- Rhomboid major muscle
- Rhomboid minor muscle
- Risorius muscle
- Rotatores cervicis muscle
- Scalenus anterior muscle (Anterior scalene muscle)
- Scalenus posterior muscle (Posterior scalene muscle)
- Scalenus medius muscle (middle scalene muscle)
- Semispinalis capitis muscle
- Semispinalis cervicis muscle
- Serratus anterior muscle
- Serratus posterior superior muscle
- Splenius capitis muscle
- Splenius cervicis muscle
- Spinalis cervicis muscle
- Sternocleidomastoid muscle
- Sternohyoid muscle
- Sternothyroid muscle
- Styloglossus muscle
- Stylopharyngeus muscle
- Stylohyoid muscle
- Subclavius muscle
- Superior belly of omohyoid muscle
- Superior constrictor muscle of pharynx
- Superior longitudinal lingual muscle
- Supraspinatus muscle
- Temporalis muscle (face)
- Tensor veli palatini muscle
- Levator veli palatini muscle
- Thyroarytenoid muscle
- Thyrohyoid muscle
- Transverse arytenoid muscle
- Oblique arytenoid muscle
- Transverse muscle of tongue
- Trapezius muscle
- Vocalis muscle
- Zygomaticus major muscle
- Zygomaticus minor muscle
- Anterior atlanto-occipital membrane
- Aryepiglottic fold
- Auditory tube
- Buccopharyngeal fascia
- Carotid canal
- Cervical part of esophagus
- Choana
- Clivus
- Common nasal meatus
- Conus elasticus
- Cruciate ligament of the atlas
- Dorsum of nose
- Epiglottic vallecula
- Epiglottis
- Foramen cecum of tongue
- Glottis
- Gum (gingiva)
- Hyoepiglottic ligament
- Incisive duct
- Infraglottic cavity
- Intracanalicular part of optic nerve
- Jugular foramen
- jugular foramen pars nervosa
- Jugular foramen pars vascularis
- Laryngeal inlet
- Laryngeal ventricle
- Laryngeal vestibule
- Laryngopharynx
- Lateral glossoepiglottic fold
- Lingual Septum
- Lingual tonsil
- Lower lip
- Median glossoepiglottic fold
- Meckel’s cave (Trigeminal cave)
- Mental foramen
- Nasal vestibule
- Nasopharynx
- Nuchal ligament
- Opening of nasolacrimal duct
- Oropharynx
- Orbital part of orbicularis oculi muscle
- Palatine glands
- Palatine tonsil
- Parotid duct
- Posterior atlanto-occipital ligament
- Preseptal part of orbicularis oculi muscle
- Pterygomandibular raphe
- Root of tongue
- Salpingopalatine fold
- Salpingopharyngeal fold
- Spinal cord
- Sublingual gland
- Submandibular duct
- Submandibular gland
- Tectorial Membrane
- Thyrohyoid membrane
- Thyroepiglottic ligament
- Tonsillar fossa
- Uvula of palate
- Vestibular fold & vestibular ligament
- Anterior arch of atlas
- Anterior nasal spine
- Arch of cricoid cartilage
- Arytenoid cartilage
- Body of hyoid bone
- Body of mandible
- Central inferior incisor tooth
- Central superior incisor tooth
- Clavicle
- Condylar canal
- Costotransverse joint
- Cricoid cartilage
- Dens of axis
- External occipital protuberance
- First rib
- Foramen ovale
- Foramen spinosum
- Frontal process (zygomatic bone)
- Greater alar cartilage
- Greater horn of hyoid bone
- Greater wing of sphenoid bone
- Hyoid bone
- Inferior alveolar foramen (mandibular foramen)
- Inferior canine tooth
- Inferior cornu of thyroid cartilage
- Inferior first premolar tooth
- Inferior second molar tooth
- Inferior second premolar tooth
- Inferior third molar tooth
- Lateral inferior incisor tooth
- Lateral superior incisor tooth
- superior canine tooth
- Superior first molar tooth
- Superior first premolar tooth
- Superior second molar tooth
- Superior second premolar tooth
- Superior third molar tooth
- Inferior nasal concha
- Inferior orbital fissure
- Lamina of cricoid cartilage
- Lamina of thyroid cartilage
- Lateral mass of atlas
- Margin of tongue
- Maxilla
- Maxillary sinus
- Median atlantoaxial joint
- Middle nasal concha
- Nasal septum
- Occipital bone
- Occipital condyle
- Orbital plate
- Orbital surface of maxilla
- Palatine process of maxilla
- Posterior arch of atlas
- Scapula
- Sella turcica
- Superior cornu of thyroid cartilage
- Superior nasal concha
- Thyroid cartilage
- Vomer
- Zygomatic arch
- Zygomatic bone
- Posterior superior alveolar nerve
- Anterior superior alveolar nerve
- Middle superior alveolar nerve
- Mandibular foramen
- Root of lower molar tooth
- Lower molar apical foramen
- Upper premolar apical foramen
- Root of upper molar tooth
- Root canal of upper molar tooth
- Dental pulp of upper molar tooth
- Dental pulp of upper premolar tooth
- Enamel of canines tooth
- Enamel of lower molar tooth
- Mandibular nerve
- Submandibular lymph nodes
- Root canal of upper premolar tooth
- Root canal of upper canines tooth
- Enamel of upper molar tooth
- Enamel of upper incisor tooth
- Enamel of lower canines tooth
- Enamel of lower incisor tooth
- Enamel of lower premolar tooth
- Dental pulp of lower molar tooth
- Root canal of lower canines tooth
- Alveolar ridge
- Root canal of lower premolar tooth
- Lower premolar apical foramen
- Dental branches of inferior alveolar artery, vein, & nerve
- Alveolar process of maxilla
- Superior dental plexus
- Root of lower canines tooth
- Body of tongue
- Dorsum of tongue
- Malar (zygomatic) lymph nodes
- Preauricular lymph nodes
- Nasolabial lymph nodes
- Superficial parotid lymph nodes
- Buccinator lymph nodes
- Deep parotid lymph nodes
- Retropharyngeal lymph nodes
- Mastoid lymph nodes
- Occipital lymph nodes
- Superior deep cervical lymph nodes
- Mandibular lymph nodes
- Lingual lymph nodes
- Jugulodigastric lymph nodes
- Accessory lymph nodes
- Submental lymph nodes
- Superficial lateral cervical lymph nodes
- Middle deep cervical lymph nodes
- Superficial anterior cervical lymph nodes
- Thyroid lymph nodes
- Paratracheal lymph nodes
- Inferior deep cervical lymph nodes
- Supraclavicular lymph nodes
- Axis (C2 vertebra)
- C3–C4 intervertebral disc
- Anulus fibrosus of intervertebral disc
- Nucleus pulposus of intervertebral disc
- Lamina of vertebra
- Spinous process of vertebra
- Facet joint of vertebra (Zygapophyseal joints)
- Atlantooccipital joint
- Anterior tubercle of atlas
- Lateral atlantoaxial joint
- Transverse process of atlas
- Anterior longitudinal ligament
- Posterior longitudinal ligament
- Ligamenta flava (Ligamentum flavum)
- Interspinous ligament
- Alar ligament
- Anterior atlantooccipital membrane
- Posterior atlantooccipital membrane
- Levator scapulae muscle
- Right vertebral artery
- Left vertebral artery
- Right vertebral artery (cervical part)
- Right vertebral artery (atlantic part)
- Right Vertebral Artery (Intracranial Part)
- Left Vertebral Artery (Intracranial Part)
- Left vertebral artery (atlantic part)
- Left vertebral artery (cervical part)
- subarachnoid space of spinal cord
- Ventral root of spinal nerve
- Dorsal root of spinal nerve
- Cisterna magna
- Body of vertebra
- Pedicle of vertebra
- Transverse process of vertebra
- Superior articular process of vertebra
- Inferior articular process of vertebra
- Intervertebral Disc
- Rotatores cervicis muscles
- Oblique and transverse arytenoid muscles
- Inferior constrictor muscle of pharynx
- Pharyngeal raphe
- Exit foramina
- Transverse foramen
- Premedullary cistern
- Median aperture of fourth ventricle (foramen of Magendie)
- Median sulcus of rhomboid fossa
- Cerebellopontine cistern
- Lateral aperture of fourth ventricle (foramen of Luschka)
- Sylvian cistern
- Cerebral aqueduct
- Choroid fissure
- Superior opening of cerebral aqueduct
- Collateral trigone
- Transverse pontine vein
- Inferior cerebellar veins
- Lateral occipital artery
- Flocculus
- Crus I of ansiform lobule of cerebellum
- Crus II of ansiform lobule of cerebellum
- Paramedian lobule (HVII) of cerebellum
- Simple lobule (HVI) of cerebellum
- Anterior quadrangular lobule (HV) of cerebellum
- Anterior quadrangular lobule (HlV) of cerebellum
- Biventral lobule (HVIII) of cerebellum
- White matter of cerebellum (Arbor vitae)
- Intrabiventral Fissure of Biventral Lobule
- Lunogranicile fissure of cerebellum
- Medial occipital artery
- Posterior inferior cerebellar artery
- Lingula of cerebellum (I)
- Central lobule (II & III) of Cerebellum
- Culmen (IV, V) of Cerebellum
- Declive (VI) of Cerebellum
- Folium (VII) of Cerebellum
- Tuber of vermis (VII)
- Pyramid of vermis (VIII)
- Uvula of vermis (IX)
- Nodule of vermis (X)
- Cerebellar tonsil (H IX)
- Pineal gland
- Calcarine artery
- Parieto-occipital artery
- Posterior hippocampal artery
- Anterior parietal artery
- Rolandiс artery
- Pre-Rolandic artery
- Frontopolar artery
- Temporopolar artery
- Lateral orbitofrontal artery
- Medial orbitofrontal artery
- Middle meningeal artery
- Anterior cerebral artery (A1 Segment)
- Anterior cerebral artery (A2 Segment)
- Anterior cerebral artery (A3 Segment)
- Posterior cerebral artery (P1 Segment)
- Posterior cerebral artery (P2 Segment)
- Posterior cerebral artery (P3 Segment)
- Posterior cerebral artery (P4 Segment)
- Middle cerebral artery horizontal segment (M1)
- Middle cerebral artery insular segment (M2)
- Middle cerebral artery opercular segment (M3)
- Middle cerebral artery cortical segment (M4)
- Superior cortical veins
- Deep middle cerebral vein
- Posterior vein of septum pellucidum
- Vein of cerebellomedullary cistern
- Inferior vermian vein
- Superior vermian vein
- Inferior choroidal vein
- Angular vein
- Supratrochlear veins
- Common facial vein
- Lingual vein
- Posterior external vertebral venous plexus
- Anterior internal vertebral venous plexus
- Anterior external vertebral venous plexuses
- Body of hippocampus
- Head of hippocampus
- Tail of hippocampus
- Hippocampus
- Anterior hippocampal veins
- Choroid plexus
- Thoracic part of esophagus
- Trachea
- Right lobe of thyroid gland
- Left lobe of thyroid gland
- Thyroid gland
- Left lobe of liver
- Right lobe of liver
- Liver
- Manubrium of sternum
- Body of sternum
- Xiphoid process of sternum
- Sternum
- Pericardium
- Heart
- Left ventricle
- Right atrium
- Left atrium
- Right ventricle
- Left auricle
- Coronary sinus
- Pulmonary trunk
- Pulmonary valve
- Conus arteriosus
- Interventricular Septum
- Left atrioventricular valve (mitral or bicuspid valve)
- Right atrioventricular valve (tricuspid valve)
- Aortic sinus
- Aortic root
- Ascending aorta
- Arch of aorta
- Descending thoracic aorta
- Thymus
- Thymic veins
- Spleen
- Gallbladder
- Pancreas
- Fundus of stomach
- Body of stomach
- Cardia of stomach
- Pylorus of stomach
- Pyloric canal
- pyloric antrum
- Transverse colon
- Descending colon
- Esophagus
- Costal cartilages
- Costal notches
- Costochondral joints
- Costovertebral joint
- Costoxiphoid ligaments
- Sternocostal joint
- Sternocostal synchondrosis of first rib
- Pleura
- Sternal part of diaphragm
- Costal part of diaphragm
- Lumbar part of diaphragm
- Left hemidiaphragm
- Right hemidiaphragm
- Diaphragm
- Crura of diaphragm
- Right crus of diaphragm
- Median arcuate ligament
- Axillary lymph nodes
- Infraclavicular lymph nodes
- Right main bronchus
- Left main bronchus
- Right apical segmental bronchus (B1)
- Left apicoposterior bronchus (B1+2a, B1+2b)
- Right posterior segmental bronchus (B2, B2a, B2b)
- Right anterior segmental bronchus (B3)
- Left anterior segmental bronchus (B3a, B3b, B3c)
- Superior lingular bronchus of left lung (B4)
- Inferior lingular bronchus of left lung (B5)
- Left inferior lobar bronchus
- Right middle lobe bronchus
- Right lung (superior lobe)
- Right lung (middle lobe)
- Right lung (inferior lobe)
- Left Lung (Superior Lobe)
- Left lung (inferior lobe)
- Oblique fissure of left lung
- Oblique fissure of right lung
- Horizontal fissure of right lung
- Lingular bronchus of left lung
- Left superior lobar bronchus
- Anteromedial basal bronchus of left lung (B7+8)
- Posterior basal segmental bronchus of left lung (B10)
- Lateral basal segmental bronchus of left lung (B9)
- Posterior basal segmental bronchus of right lung (B10)
- Lateral basal segmental bronchus of right lung (B9)
- Anterior basal segmental bronchus of right lung (B7+8, B8)
- Medial segmental bronchus of right lung (B5)
- Superior segmental bronchus of right lung (B6)
- Right intermediate bronchus
- Right adrenal gland
- Left adrenal gland
- Adrenal glands
- Posterior sternoclavicular ligament
- Superior sternopericardial ligaments
- Sternal end of the clavicle
- Thoracoacromial artery
- Subscapular artery
- Thoracodorsal artery
- Lateral thoracic artery
- Circumflex scapular artery
- Dorsal scapular artery
- Suprascapular artery
- Superior intercostal artery
- Thyrocervical trunk
- Axillary artery
- Left common carotid artery
- Internal thoracic artery
- Superior phrenic artery
- Posterior intercostal arteries
- Right hepatic artery
- Left hepatic artery
- Left gastric artery
- Proper hepatic artery
- Gastroduodenal artery
- Common hepatic artery
- Splenic artery
- Celiac trunk
- Abdominal aorta
- left gastro-omental artery (left gastroepiploic artery)
- Short gastric arteries
- Left anterior descending artery (LAD)
- Circumflex artery (LCx)
- Left main coronary artery (LMCA)
- Right coronary artery (RCA)
- First diagonal branch (D1) of LAD
- Second diagonal branch (D2) of LAD
- Third diagonal branch (D3) of LAD
- Sinoatrial nodal artery
- Conus artery
- Acute marginal artery (AM)
- Interventricular septal branch S1
- Interventricular septal branch S2
- Left marginal vein
- First obtuse marginal branch
- Anterior interventricular sulcus
- Small cardiac vein
- Great cardiac vein
- Middle cardiac vein
- Posterior vein of left ventricle
- Right marginal vein of heart
- Valve of coronary sinus
- Inferior vena cava
- Azygos vein
- Anterior leaflet of left atrioventricular valve
- Posterior leaflet of left atrioventricular valve
- Pectinate muscles
- Sulcus terminalis of heart
- Trabeculae carneae
- Anterior papillary muscle
- Posterior papillary muscle
- Myocardium
- Endocardium
- Epicardium
- Coronary sulcus
- Posterior interventricular sulcus
- Pericardial cavity
- Thoracic duct
- Sinoatrial node (SA node)
- Atrioventricular Node (AV Node)
- Atrioventricular bundle (bundle of His)
- Right branch of atrioventricular bundle
- Left branch of atrioventricular bundle
- Oblique vein of left atrium
- Left atrial branch (coronary artery)
- Openings of pulmonary veins
- Oval fossa of right atrium
- Right fibrous trigone
- Right auricle of heart
- Aortic vestibule
- Interatrial septum
- Noncoronary aortic sinus
- Aortic valve
- Superior vena cava
- Opening of superior vena cava
- Opening of inferior vena cava
- Sinus of venae cavae (sinus venarum)
- Hemiazygos vein
- Superior tracheobronchial lymph nodes
- Subcarinal lymph nodes
- Interlobar lymph nodes
- Inferior tracheobronchial lymph nodes
- Transverse pericardial sinus
- Oblique pericardial sinus
- Middle lobar artery of right lung
- Inferior lobar artery of right lung
- Lateral segmental artery of right Lung
- Anterior basal segmental artery of right lung
- Lateral basal segmental artery of right lung
- Posterior basal segmental artery of right lung
- Anterior basal segmental artery of left lung
- Posterior basal segmental artery of left lung
- Lateral basal segmental artery of left lung
- Right superior pulmonary vein
- Right inferior pulmonary vein
- Left superior pulmonary vein
- Left inferior pulmonary vein
- Right middle lobe vein
- Superior vein of right lung
- Medial vein of right lung
- Lateral vein of right lung
- Common basal vein of right lung
- Posterior basal vein of right lung
- Lateral basal vein of right lung
- Superior vein of left lung
- Posterior basal vein of left lung
- Lingular vein of left lung
- Anterior basal vein of left lung
- Crista terminalis
- Carina of trachea
- Right superior lobar bronchus
- Right middle lobar bronchus
- Right inferior lobar bronchus
- Anterior segmental bronchus of right lung
- Apical segmental bronchus of right lung
- Apicoposterior segmental bronchus of left lung
- Superior lobar artery of right lung
- Superior lobar artery left lung
- Brachial artery
- Left pulmonary artery
- Right pulmonary artery
- Anterior segmental artery of left lung
- Anterior segmental artery of right lung
- Apical segmental artery of right lung
- Apical segmental artery of left lung
- Posterior segmental artery of left lung
- Posterior segmental artery right lung
- Superior segmental artery of left lung
- Superior segmental artery of right lung
- Superior lingular artery of left lung
- Medial segmental artery of right lung
- Inferior phrenic artery
- Splenic branches of splenic artery
- Right interlobar artery
- Left interlobar artery
- Subsuperior segmental artery of right lung
- Jugular venous arch
- Inferior thyroid vein
- Vertebral vein
- Left brachiocephalic vein
- Left subclavian vein
- Right subclavian vein
- Axillary veins
- Brachial veins
- Thoracodorsal vein
- Dorsal scapular vein
- Suprascapular vein
- Right brachiocephalic vein
- Intermediate hepatic vein
- Right hepatic vein
- Left hepatic vein
- Left gastro-omental (gastroepiploic) vein
- Short gastric veins
- Hepatic portal vein
- Splenic vein
- Inferior phrenic vein
- Anterior vein of left lung
- Anterior vein of right lung
- Posterior vein of right lung
- Superior lingular vein of left lung
- Inferior lingular vein of left lung
- Tracheal bifurcation
- Posterior segmental bronchus of right lung
- Lateral segmental bronchus of right lung
- Glenoid fossa
- Glenoid process of scapula
- Spine of scapula
- Acromion process of scapula
- Coracoid process of scapula
- Scapular body
- supraspinous fossa of scapula
- Subscapular fossa
- Neck of scapula
- Humerus
- Head of humerus
- Body of humerus
- Shaft (body) of clavicle
- Acromial end of clavicle
- Sternoclavicular joint
- Costovertebral joint of first rib (rib head joint)
- Costotransverse joint of first rib
- Tubercle of rib
- Ribs
- Intra-articular ligament of head of rib
- Pectoralis minor muscle
- Latissimus dorsi muscle
- Coracobrachialis muscle
- Teres major muscle
- Subscapularis muscle
- Teres minor muscle
- Infraspinatus muscle
- Rotatores muscle
- Semispinalis muscle
- Spinalis muscle
- Iliocostalis muscle
- Longissimus muscle
- Levatores costarum muscle
- Rectus abdominis muscle
- External oblique muscle
- Serratus posterior inferior muscle
- Brachial plexus
- Spinal nerves
- Left recurrent laryngeal nerve
- Left phrenic nerve
- Intervertebral foramina
- Intertransverse ligament
- Costotransverse ligament
- Basivertebral veins
- Anterior cecal artery
- Appendicular artery
- Cystic artery
- Ileal arteries
- Ileocolic artery
- Ileocolic artery colic branches
- Ileocolic artery ileal branches
- Inferior mesenteric artery (IMA)
- Interlobar arteries of kidney
- Jejunal arteries
- Left colic artery
- Marginal artery of Drummond
- Middle colic artery
- Omental branches of gastro-omental (gastroepiploic) artery
- Right posterior descending coronary artery (Right PDA)
- Distal left anterior descending artery (dLAD)
- Right colic artery
- Right gastric artery
- Superior epigastric artery
- Superior mesenteric artery (SMA)
- Superior rectal artery
- Accessory hepatic vein
- Great pancreatic vein
- Left branch of hepatic portal vein
- Right branch of hepatic portal vein
- Portal vein branch to liver segment I
- Portal vein branch to liver segment II
- Portal vein branch to liver segment III
- Portal vein branch to liver segment IV
- Portal vein branch to liver segment V
- Portal vein branch to liver segment VI
- Portal vein branch to liver segment VII
- Portal vein branch to liver segment VIII
- Right gastric vein
- Internal thoracic veins
- Left internal thoracic veins
- Right internal thoracic veins
- Right internal thoracic artery
- Left internal thoracic artery
- Right ovarian vein
- Left ovarian vein
- Superior epigastric veins
- Sigmoid veins
- Vasa recta (kidney)
- Superior mesenteric vein
- Superior rectal vein
- Posterior intercostal veins
- Abdominal part of esophagus
- Ascending colon
- Cardia of stomach
- Cecum
- Duodenum – Superior part (D1)
- Duodenum – Descending part (D2)
- Duodenum – Horizontal part (D3)
- Duodenum – Ascending part (D4)
- Fundus of gallbladder
- Body of gallbladder
- Neck of gallbladder
- Ileocaecal valve (ileocecal junction)
- Jejunum
- Ileum
- Terminal ileum
- Small intestine
- Stomach
- Transverse mesocolon
- Descending mesocolon
- Ascending mesocolon
- Right paracolic gutter
- Left paracolic gutter
- kidneys
- Right kidney
- Left kidney
- Kidney cortex (Renal cortex)
- Renal capsule
- Renal medulla
- Renal pyramids
- Adrenal gland
- Ureters
- Left ureter
- Right ureter
- Ureteropelvic junction
- Renal fascia
- Renal artery
- Renal vein
- Left renal vein
- Right renal vein
- Paraesophageal lymph nodes
- Prepericardial lymph nodes
- Superior diaphragmatic lymph nodes
- Superior mesenteric lymph nodes
- Lateral aortic lymph nodes
- Lesser curvature lymph nodes
- Apex of the heart
- Phrenicomediastinal recess
- Crural part of diaphragm
- Phrenoesophageal ligament
- Internal oblique muscle
- Transversus abdominis muscle
- Iliacus muscle
- Psoas major muscle
- Quadratus lumborum muscle
- Intercostal muscles
- Interspinales muscles
- Intertransversarii muscle
- Gluteus maximus muscle
- Gluteus medius muscle
- Gluteus minimus muscle
- Transversus thoracis muscle
- Cauda equina
- Conus medullaris
- Aortic bifurcation
- Ala of ilium (wing of ilium)
- Iliac crest
- Iliac tubercle
- Sacrum
- Ala of sacrum
- Coccyx
- Median sacral crest
- Sacral canal
- Posterior sacral foramina
- Anterior sacral foramina
- Posterior superior iliac spine
- Posterior inferior iliac spine
- Transverse processes
- Sacroiliac joint
- Supraspinous ligament
- Falciform ligament (liver)
- Ligamentum teres (round ligament of the liver)
- Umbilical vein
- Ligamentum venosum
- Fissure for ligamentum venosum
- Fissure for ligamentum teres
- Linea alba
- Lumbar triangle
- Parietal peritoneum
- Preperitoneal space
- Quadrate lobe of liver
- Caudate lobe of liver
- Liver Segment I – Caudate lobe
- Liver Segment II – Left lateral superior segment
- Liver Segment III – Left lateral inferior segment
- Liver Segment IVa – Left medial superior segment
- Liver Segment IVb – Left medial inferior segment
- Liver Segment V – Right anteroinferior segment
- Liver Segment VI – Right posteroinferior segment
- Liver Segment VII – Right posterosuperior segment
- Liver Segment VIII – Right anterosuperior segment
- Acetabular margin (Acetabular rim)
- Acetabulum
- Anterior acetabular wall
- Posterior acetabular wall
- Anterior superior iliac spine
- Anterior inferior iliac spine
- Body of femur
- Body of ilium
- Body of ischium
- Body of pubis
- Ilium bone
- Ischium bone
- Pubic bone
- Greater sciatic notch
- Greater trochanter
- Lesser trochanter
- Head of femur
- Neck of femur
- Iliopubic eminence
- Inferior pubic ramus
- Intertrochanteric line
- Ischial spine
- Ischial tuberosity
- Ramus of ischium
- Superior pubic ramus
- Pudendal nerve
- Sciatic nerve
- Obturator nerve
- Accessory obturator artery
- Deep circumflex iliac artery
- Inferior gluteal artery
- Lateral circumflex femoral artery
- Deep femoral artery (profunda femoris)
- External iliac artery
- Femoral artery
- Internal iliac artery
- Medial circumflex femoral artery
- Obturator artery
- Superficial femoral artery
- Pudendal artery
- Superficial circumflex iliac artery
- Umbilical artery
- Uterine artery
- Superior gluteal artery
- Accessory obturator vein
- Accessory saphenous vein
- Inferior gluteal vein
- Lateral circumflex femoral veins
- External iliac vein
- Femoral vein
- great saphenous vein
- Internal iliac vein
- Medial circumflex femoral vein
- Obturator vein
- Pudendal vein
- Superficial circumflex iliac vein
- Uterine venous plexus
- Vaginal venous plexus
- Common iliac vein
- Union of common iliac veins
- common iliac artery
- Adductor brevis muscle
- Adductor longus muscle
- Adductor magnus muscle
- Adductor minimus muscle
- Coccygeus muscle
- External anal sphincter
- Internal anal sphincter
- Gracilis muscle
- Inferior gemellus muscle
- Superior gemellus muscle
- Levator ani muscle
- Obturator externus muscle
- Obturator internus muscle
- Pectineus muscle
- Puborectalis muscle
- Pyramidal muscle (pyramidalis muscle)
- Rectus femoris muscle
- Sartorius muscle
- Tensor fasciae latae muscle
- Vastus lateralis muscle
- Vastus medialis muscle
- Anal canal
- Anococcygeal body (anococcygeal ligament)
- Iliofemoral ligament
- Iliotibial tract
- Female urethra
- Inferior pubic ligament
- Superior pubic ligament
- Inguinal ligament
- Inguinal lymph nodes
- Internal urethral orifice
- Intermediate lacunar external iliac lymph nodes
- Ischioanal fossa
- External iliac lymph nodes
- Median umbilical ligament
- Mesorectal fascia
- Uterosacral ligament
- Mesorectum
- Obturator lymph nodes
- Pubic symphysis
- Rectovaginal septum (rectovaginal fascia)
- Rectum
- Sacrospinous ligament
- Sacrotuberous ligament
- Vesicovaginal space
- Urinary bladder
- Iliopsoas tendon
- Uterus
- Body of uterus
- Fundus of uterus
- Cervix of uterus
- Isthmus of uterus
- Vagina
- Fornix of the vagina
- Endometrium of uterus
- Myometrium of uterus
- Perimetrium of uterus
- Junctional zone of uterus
- Ovaries
- Right ovary
- Left ovary
- Fallopian tube
- Suspensory ligament of ovary
- Broad ligament of uterus
- Round ligament of uterus
- Piriformis muscle
- Saphenous nerve
- Muscular branches of femoral nerve
- Lateral femoral cutaneous nerve
- Obturator veins
- Posterior division of obturator nerve (Posterior branch of obturator nerve)
- Anterior division of obturator nerve (Anterior branch of obturator nerve)
- Coccygeal nerve
- Coccygeal plexus
- Uterine horn
- Endocervical canal
- Stroma of the cervix
- Internal os of the cervix
- External os of the cervix
- Vesicouterine pouch
- Rectouterine pouch (pouch of Douglas)
- Mons pubis
- Pubic tubercle
- Retropubic space
- Urethrovaginal space
- External urethral sphincter (female)
- Internal urethral sphincter (female)
- Internal urethral sphincter (male)
- External urethral sphincter (male)
- Superficial transverse perineal muscle
- Deep transverse perineal muscle
- Ischiocavernosus muscle (Female)
- Bulbospongiosus muscle (Female)
- Bulbospongiosus muscle (Male)
- Ischiocavernosus muscle (Male)
- Labia majora
- Labia minora
- Clitoris
- Skene’s gland (paraurethral glands)
- Vestibular fossa
- External urethral orifice
- Rectococcygeal muscle
- Vas deferens
- Inferior epigastric artery
- Inferior epigastric veins
- Superior vesical artery
- Inferior vesical artery
- Testicular artery
- Vesical veins
- Vesical venous plexus
- Posterior femoral cutaneous nerve
- Gluteal lymph nodes
- Sacral lymph nodes
- Puboprostatic ligament
- Trigone of urinary bladder
- Apex of urinary bladder
- Neck of urinary bladder
- Fundus of urinary bladder
- Body of urinary bladder
- Seminal vesicle
- Ejaculatory duct
- Peripheral zone of prostate
- Anterior Fibromuscular Stroma of prostate
- Central zone of prostate
- Transitional zone of prostate
- Obturator internus tendon
- Obturator externus tendon
- Puboprostaticus muscle
- Puboanalis muscle
- Pubococcygeus muscle
- Iliococcygeus muscle
- Ischiococcygeus muscle
- Membranous urethra
- Prostatic urethra
- Penile urethra
- Rectoprostatic fascia (Denonvilliers' fascia)
- Rectosacral fascia (Waldeyer's fascia)
- Presacral fascia
- Fascia of pelvic diaphragm
- Rectal proper fascia (Fascia propria of the rectum)
- Genitofemoral nerve
- Femoral nerve
- Anterior lateral femoral cutaneous nerve
- Posterior lateral femoral cutaneous nerve
- Intercommunicating branches of L3–L4 nerves
- Traversing nerve root of spinal nerve
- Exiting nerve root of spinal nerve
- Spinal nerve L1
- Spinal nerve L2
- Spinal nerve L3
- Spinal nerve L4
- Spinal nerve L5
- Spinal nerve S1
- Spinal nerve S2
- Spinal nerve S3
- Spinal nerve S4
- Iliohypogastric nerve
- Ilioinguinal nerve
- Superior cluneal nerves
- Medial cluneal nerves
- Superior gluteal nerve
- Lumbosacral trunk
- Sacral plexus
- Inferior rectal nerve
- Perineal nerves
- Dorsal ramus of spinal nerve
- Inferior gluteal nerve
- Sacral splanchnic nerves
- Anococcygeal nerve
- Spermatic cord
- Cremaster muscle
- Bulbourethral gland (Cowper’s glands)
- Rectovesical pouch
- Spermatic cord nerves
- Pampiniform plexus
- Transverse perineal muscle
- Buck's fascia (Deep fascia of penis)
- Dartos fascia
- Areolar tissue of penis
- Subcutaneous tissue (scrotum)
- Septum of the penis (Penile septum)
- Corpus cavernosum
- Corpus spongiosum
- Bulb of Penis
- Crus of penis
- Head of epididymis
- Tail of epididymis
- Body of epididymis
- Epididymis
- Deep dorsal vein of the penis
- Superficial dorsal vein of penis
- Foreskin
- Glans penis
- Corona of glans penis
- Coronal sulcus
- Meatus of the urethra
- Testis
- Tunica albuginea (penis)
- Tunica albuginea of testis
- Septum of scrotum
- Skin of scrotum
- External spermatic fascia
- Cremaster fascia
- Internal spermatic fascia
- Parietal tunica vaginalis
- Lobule of testis
- Mediastinum testis
- Visceral tunica vaginalis
- Scrotal fluid
- Septum of testis
- Anterior sacroiliac ligament
- Interosseous sacroiliac ligament
- Posterior sacroiliac ligament
- Uterine veins
- Sigmoid colon
- Sacral venous plexus
- Superior gluteal veins
- Lateral sacral artery
- Lateral sacral vein
- Median sacral vein
- Internal iliac lymph nodes
- Lateral part of sacrum
- Transverse ridges
- Sacral cornu (sacral horn)
- Sacral hiatus
- Intermediate sacral crest
- Mesorectal free fluid
- Lumbar arteries
- Common iliac lymph nodes
- Spinal nerve S5
- Spinal nerve Co1
- Iliolumbar ligament
- Lumbosacral joint
- Superior articular process of S1 vertebra
- Inferior articular process of L5 vertebra
- Lateral sacral crest
- Exiting nerve root of spinal nerve S1
- Traversing nerve root of spinal nerve S1
- Traversing nerve root of spinal nerve S2
- Traversing nerve root of spinal nerve S3
- Traversing nerve root of spinal nerve S4
- Exiting nerve root of spinal nerve S2
- Exiting nerve root of spinal nerve S3
- Exiting nerve root of spinal nerve S4
- Exiting nerve root of spinal nerve S5
- Filum terminale internum
- Lumbar veins
- Renal pelvis
- Vertebral venous plexus
- Common bile duct
- Left crus of diaphragm
- Right lumbar part of diaphragm
- Left lumbar part of diaphragm
- Thoracolumbar fascia (posterior layer)
- Thoracolumbar fascia (middle layer)
- Thoracolumbar fascia (anterior layer)
- Costovertebral joint of twelfth rib
- Costotransverse joint of twelfth rib
- Head of twelfth rib
- Mammillary process of vertebra
- Accessory process of vertebrae
- Spinal dura mater
- Spinal epidural space
- Dorsal traversing nerve root
- Ventral traversing nerve root
- Dorsal exiting nerve root
- Ventral exiting nerve root
- Dorsal root ganglion of spinal nerve
- Iliocostalis lumborum muscle
- Longissimus thoracis muscle
- Spinalis thoracis muscle
- Rotatores thoracis muscles
- Rotatores lumborum muscles
- Lateral intertransversarii lumborum muscle
- Medial intertransversarii lumborum
- Interspinales lumborum muscle
- Annulus fibrosus of intervertebral disc
- Iliac tuberosity
- Inferior mesenteric vein
- L5–S1 Intervertebral disc
- L4–L5 Intervertebral Disc
- L3–L4 Intervertebral Disc
- L2–L3 Intervertebral Disc
- L1–L2 Intervertebral Disc
- T12–L1 Intervertebral Disc
- Vertebrae
- Thoracic aorta
- Duodenal bulb
- Right colic flexure (hepatic flexure)
- Left colic flexure (splenic flexure)
- Common hepatic duct
- Left hepatic duct
- Right hepatic duct
- Lateral branch of left hepatic duct
- Anterior branch of right hepatic duct
- Posterior branch of right hepatic duct
- Cystic duct
- Pancreatic duct
- Left renal artery
- Right renal artery
- Neck of pancreas
- Head of pancreas
- Uncinate process of pancreas
- Body of pancreas
- Tail of pancreas
- Accessory pancreatic duct
- Hepatopancreatic ampulla (ampulla of Vater)
- Bile duct serving liver segment I
- Bile duct serving liver segment II
- Bile duct serving liver segment III
- Bile duct serving liver segment IVa
- Bile duct serving liver segment IVb
- Bile duct serving liver segment V
- Bile duct serving liver segment VI
- Bile duct serving liver segment VII
- Bile duct serving liver segment VIII
- Placenta
- Uterus (pregnancy)
- Amniotic fluid
- Umbilical cord
- Urinary Bladder in Pregnancy
- Cervix in Pregnancy
- Vagina in Pregnancy
- Fundus of uterus in pregnancy
- Fetal brain
- Fetal caudate nucleus
- Fetal thalamus
- Fetal pons
- Fetal cerebellum
- Fetal occipital lobe
- Fetal temporal lobe
- Fetal parietal lobe
- Fetal frontal lobe
- Fetal third ventricle
- Fetal fourth ventricle
- Fetal lateral ventricle
- Fetal superior sagittal sinus
- Fetal straight sinus
- Fetal transverse sinus
- Fetal sigmoid sinus
- Fetal cervical spine
- Fetal thoracic spine
- Fetal lumbar spine
- Fetal spinal cord
- Fetal Eyes
- Fetal paranasal sinuses
- Fetal tooth buds
- Maternal ovaries
- Fetal shoulder
- Fetal lungs
- Fetal Ribs
- Fetal trachea
- Fetal Heart
- Fetal aorta
- Fetal upper arm
- Fetal knee
- Fetal ankle
- Fetal foot
- Fetal thigh
- Fetal Lower Leg
- Fetal forearm
- Fetal Liver
- Fetal small bowel
- Fetal hand
- Fetal urinary bladder
- Fetal kidneys
- Fetal rectum
- Fetal elbow
- Fetal wrist
- Fetal hip
- Fetal anus
- Fetal Fingers
- Fetal buttock
- Fetal scrotum
- Fetal testis
- Fetal penis
- Fetal colon
- Fetal stomach
- Fetal spinal canal
- Iliopsoas muscle
- Vastus intermedius muscle
- Quadratus femoris muscle
- Erector spinae muscles
- Rectus femoris tendon (Proximal tendon of rectus femoris)
- Sartorius Tendon (Proximal)
- Gluteus minimus tendon
- Gluteus medius tendon
- Tensor fasciae latae tendon
- Conjoint tendon of biceps femoris & semitendinosus
- Semimembranosus tendon (proximal)
- Deep femoral vein (profunda femoris vein)
- Femoral shaft
- Femur
- Ischiopubic ramus
- Superficial inguinal lymph nodes
- Pubofemoral ligament
- Zona orbicularis ligament
- Ligamentum teres (ligament of the head of femur)
- Acetabular labrum
- Ischiofemoral ligament
- Transverse acetabular ligament
- Iliofemoral Ligament superior band (transverse band, lateral band)
- Iliofemoral Ligament inferior band (vertical band, medial band)
- Articular capsule of hip joint
- Biceps femoris muscle (Short head)
- Biceps femoris muscle (Long head)
- Semitendinosus muscle
- Semimembranosus muscle
- Gracilis Tendon (Proximal)
- Plantaris muscle
- Lateral head of gastrocnemius muscle
- Medial head of gastrocnemius muscle
- Gastrocnemius muscle
- Popliteus muscle
- Soleus muscle
- Vastus Lateralis Obliquus Muscle
- Extensor digitorum longus muscle
- Tibialis anterior muscle
- Fibularis longus muscle (peroneus longus muscle)
- Patellar tendon (patellar ligament)
- Medial gastrocnemius tendon
- Lateral gastrocnemius tendon
- Distal biceps femoris tendon
- Distal semimembranosus tendon
- Distal semitendinosus tendon
- Gracilis tendon (Distal)
- Sartorius tendon (Distal)
- Distal quadriceps femoris tendon
- Distal vastus intermedius tendon
- Distal rectus femoris tendon
- Distal vastus medialis tendon
- Distal vastus lateralis tendon
- Popliteus tendon
- Distal adductor magnus tendon
- Medial collateral ligament
- Lateral collateral ligament
- Anterior cruciate ligament
- Posterior cruciate ligament
- Anterolateral ligament of knee
- Posterior meniscofemoral ligament
- Anterior meniscofemoral ligament
- Oblique popliteal ligament
- Arcuate popliteal ligament
- Medial patellofemoral ligament
- Lateral patellofemoral ligament
- Medial patellar retinaculum
- Lateral patellar retinaculum
- Transverse ligament of knee
- Anterior ligament of fibular head
- Posterior ligament of fibular head
- Popliteal artery
- Descending genicular artery (Saphenous branch)
- Descending genicular artery (Articular branches)
- Superior medial genicular artery
- Superior lateral genicular artery
- Perforating Arteries (Knee joint)
- Popliteal vein
- Inferior lateral genicular artery
- Small saphenous vein
- Superior lateral genicular vein
- Superior medial genicular vein
- Inferior lateral genicular vein
- Popliteal–Saphenous perforating veins
- Medial epicondyle of femur
- Lateral epicondyle of femur
- Lateral condyle of femur
- Medial condyle of femur
- Femoral condyle articular cartilage
- Tibial condyle articular cartilage
- Body of tibia
- Tibial tuberosity
- Lateral intercondylar tubercle
- Medial intercondylar tubercle
- Tibia
- Fibula
- Head of fibula
- Neck of fibula
- Medial tibial plateau
- Lateral tibial plateau
- Base of patella
- Apex of patella
- Medial border of patella
- Lateral border of patella
- Medial articular facet of patella
- Lateral articular facet of patella
- Patella
- Patellar articular cartilage
- Infrapatellar fat pad
- Suprapatellar fat pad
- Prefemoral fat pad
- Popliteal lymph nodes
- Trochlear groove
- Common fibular nerve
- Tibial nerve
- Muscular branches of tibial nerve
- Infrapatellar branch of saphenous nerve
- Lateral sural cutaneous nerve
- Medial sural cutaneous nerve
- Gerdy’s tubercle
- Meniscus cartilage
- Medial meniscus
- Lateral meniscus
- Anterior horn of medial meniscus
- Posterior horn of medial meniscus
- Body of medial meniscus
- Anterior root of medial meniscus
- Posterior root of medial meniscus
- Anterior horn of lateral meniscus
- Posterior horn of lateral meniscus
- Body of lateral meniscus
- Anterior root of lateral meniscus
- Posterior root of lateral meniscus
- Tibiofibular joint (proximal)
- Knee Joint
- Hip joint
- Talus
- Head of talus
- Body of talus
- Neck of talus
- Posterior talar articular facet
- Calcaneus
- Anterior process of calcaneus
- Sustentaculum tali
- Tuberosity of navicular bone
- Cuboid
- Calcaneal process of cuboid bone
- Fibula shaft
- Medial malleolus
- Lateral malleolus
- Ankle joint
- Talocalcaneal joint
- Talocalcaneonavicular joint
- Calcaneocuboid joint
- Cuneocuboid Joint
- Lateral cuneiform bone
- Medial cuneiform bone
- Intermediate cuneiform bone
- Extensor hallucis longus muscle
- Fibularis tertius muscle
- Fibularis brevis muscle
- Tibialis posterior muscle
- Flexor digitorum longus muscle
- Flexor hallucis longus muscle
- Quadratus plantae muscle
- Abductor hallucis muscle
- Extensor hallucis brevis muscle
- Extensor digitorum brevis muscle
- Flexor digitorum brevis muscle
- Abductor digiti minimi muscle
- Tibialis anterior tendon
- Extensor hallucis longus tendon
- Extensor digitorum longus tendon
- Fibularis tertius tendon
- Fibularis brevis tendon
- Fibularis longus tendon
- Tibialis posterior tendon
- Tibialis posterior tendon (medial slip)
- Tibialis posterior tendon (lateral slips)
- Tibialis posterior tendon (cuneiform insertions)
- Tibialis posterior tendon (metatarsal insertions)
- Flexor digitorum longus tendon
- Flexor hallucis longus tendon
- Plantaris tendon
- Achilles tendon
- Abductor hallucis tendon
- Quadratus plantae tendon
- Anterior talofibular ligament
- Posterior talofibular ligament
- Anterior inferior tibiofibular ligament
- Accessory anterior inferior tibiofibular (Bassett’s) ligament
- Interosseous membrane (middle tibiofibular ligament)
- Posterior inferior tibiofibular ligament
- Posterior intermalleolar ligament
- Inferior transverse ligament
- Tibionavicular ligament
- Anterior tibiotalar ligament
- Tibiocalcaneal ligament
- Superficial posterior tibiotalar ligament
- Deep posterior tibiotalar ligament
- Deltoid ligament complex
- Tibiospring Ligament
- Lateral talocalcaneal ligament
- Medial talocalcaneal ligament
- Talocalcaneal interosseous ligament
- Calcaneofibular ligament
- Calcaneonavicular ligament (Bifurcate ligament)
- Calcaneocuboid ligament (Bifurcate ligament)
- Bifurcate ligament
- Spring ligament complex
- Superomedial calcaneonavicular ligament
- Medioplantar oblique calcaneonavicular ligament
- Inferoplantar longitudinal calcaneonavicular ligament
- Dorsal calcaneocuboid ligament
- Dorsal talonavicular ligament
- Superior extensor retinaculum
- Inferior extensor retinaculum
- Superior peroneal retinaculum
- Inferior peroneal retinaculum
- Flexor retinaculum
- Fascia cruris
- Kager fat pad (pre-Achilles fat pad)
- Deep fibular nerve
- Intermediate dorsal cutaneous nerve
- Medial dorsal cutaneous nerve
- Sural nerve
- Lateral dorsal cutaneous nerve
- Anastomotic branch sural nerve
- Lateral calcaneal branches of sural nerve
- Medial calcaneal nerve
- Medial calcaneal nerve (anterior cutaneous branches)
- Medial calcaneal nerve (posterior cutaneous branches)
- Inferior calcaneal nerve (Baxter’s nerve)
- Medial plantar nerve
- Lateral plantar nerve
- Posterior tibial artery
- Anterior tibial artery
- Fibular artery
- Lateral tarsal artery
- Medial tarsal arteries
- Dorsalis pedis artery
- Lateral calcaneal artery
- Medial plantar artery
- Lateral plantar artery
- Anterior tibial veins
- Posterior tibial veins
- Fibular veins
- Lateral tarsal veins
- Lateral calcaneal veins
- Medial plantar veins
- Lateral plantar veins
- Dorsal perforator veins
- Submalleolar foot perforator veins
- Calcaneal perforator veins
- Medial perforator veins of leg
- Lateral perforator veins of leg
- Plantar aponeurosis
- Dorsal cuneocuboid ligament
- Cuneocuboid interosseous ligament
- Plantar cuneocuboid ligament
- Plantar cuboideonavicular ligament
- Plantar calcaneocuboid ligament (short plantar ligament)
- Plantar cuneonavicular ligaments
- Cockett’s perforator veins
- Superficial fibular nerve
- Interosseous membrane of leg
- Dorsal cuneonavicular ligaments
- Intercuneiform ligaments
- Dorsal intercuneiform ligaments
- Plantar intercuneiform ligaments
- Interosseous intercuneiform ligaments
- Long plantar ligament
- Dorsal metatarsal ligaments
- Metatarsal interosseous ligaments
- Plantar metatarsal ligaments
- Dorsal tarsometatarsal ligaments
- Plantar tarsometatarsal ligaments
- Lisfranc ligament
- Interosseous cuneometatarsal Ligament (Lisfranc Proper Ligament)
- First dorsal cuneometatarsal ligament (Dorsal lisfranc ligament)
- First plantar cuneometatarsal ligament (Plantar lisfranc ligament)
- Cuneonavicular joint
- Cuboideonavicular joint
- Transverse tarsal joint
- Tarsometatarsal joints
- Dorsal fascia of foot
- Deep plantar arterial arch
- Dorsal venous arch of foot
- Superficial plantar venous plexus
- Navicular perforator veins
- Cuneiform perforator veins
- Navicular bone
- First metatarsal bone
- Second metatarsal bone
- Third metatarsal bone
- Fourth metatarsal bone
- Fifth metatarsal bone
- Head of metatarsal bone
- Body of the metatarsal bone
- Base of metatarsal bone
- Dorsal digital nerve of foot
- Medial branch of deep fibular nerve
- Lateral branch of deep fibular nerve
- Proper plantar digital nerve to great toe
- Flexor hallucis brevis muscle
- Lateral head of flexor hallucis brevis muscle
- Medial head of flexor hallucis brevis muscle
- Adductor hallucis muscle
- Transverse head of adductor hallucis muscle
- Oblique head of adductor hallucis muscle
- Lumbrical muscles
- Plantar interosseous muscles
- Dorsal interosseous muscles
- Flexor digiti minimi brevis muscle
- Opponens digiti minimi muscle of foot
- First dorsal interosseous muscle of foot
- Second dorsal interosseous muscle of foot
- Third dorsal interosseous muscle of foot
- Fourth dorsal interosseous muscle of foot
- First plantar interosseous muscle of foot
- Second plantar interosseous muscle of foot
- Third plantar interosseous muscle of foot
- First lumbrical muscle of foot
- Second lumbrical muscle of foot
- Third lumbrical muscle of foot
- Fourth lumbrical muscle of foot
- Extensor hallucis brevis tendon
- Extensor digitorum longus tendons
- Extensor digitorum brevis tendons
- Flexor hallucis brevis tendons
- Flexor digitorum longus tendons
- Knot of Henry
- Flexor digitorum brevis tendons
- Abductor digiti minimi tendon
- Dorsal interossei tendons of foot
- Plantar interossei tendons of foot
- Dorsal metatarsal arteries
- Plantar metatarsal arteries
- Dorsalis pedis veins
- Dorsal metatarsal veins
- Medial tarsal veins
- Medial marginal vein of foot
- Lateral marginal vein of foot
- Plantar venous arch
- Great toe (Hallux)
- Second toe
- Third toe
- Fourth toe
- Fifth toe
- Sesamoid bone of great toe
- Lateral sesamoid bone
- Medial sesamoid bone
- Proximal phalanx of foot
- Distal phalanx of foot
- Middle phalanx of foot
- Proximal phalanx of great toe
- Distal phalanx of great toe
- Base of phalanx of foot
- Head of phalanx of foot
- Body of phalanx of foot
- Body of metatarsal bone
- Dorsal digital nerves
- Proper plantar digital nerves
- Distal interphalangeal joint of foot
- Proximal interphalangeal joints of foot
- Interphalangeal joint of great toe
- Metatarsophalangeal joints
- Digital slips of plantar aponeurosis
- Lateral collateral ligament of big toe (lateral metatarsophalangeal collateral ligament)
- Medial collateral ligament of big toe (medial metatarsophalangeal collateral ligament)
- Lateral collateral ligament of interphalangeal joint of foot
- Medial collateral ligament of interphalangeal joint of foot
- Lateral sesamoid phalangeal ligament
- Medial sesamoid phalangeal ligament
- Intersesamoid ligament
- Plantar plate ligament
- Synovial fluid
- Tendon sheath
- Extensor hood of foot
- Epidermis
- Dermis of skin
- Hypodermis of skin
- Nail (toe)
- Nail bed (toe)
- Nail root (toe)
- Lateral nail fold (toe)
- Proximal nail fold
- Conoid tubercle
- Body of scapula
- Infraspinous fossa
- Anatomical neck of humerus
- Surgical neck of humerus
- Greater tubercle of humerus
- Lesser tubercle of humerus
- Shaft of humerus
- Bicipital groove
- Circumflex subscapular artery
- Posterior circumflex humeral artery
- Cephalic vein
- Posterior circumflex humeral vein
- Axillary nerve
- Ulnar nerve
- Median nerve
- Radial nerve
- Long thoracic nerve
- Dorsal scapular nerve
- Deltoid muscle
- Scapular spinal part of deltoid muscle
- Clavicular part of deltoid muscle
- Acromial part of deltoid muscle
- Biceps brachii muscle
- Short head of biceps brachii muscle
- Long head of biceps brachii muscle
- Triceps brachii muscle
- Long head of triceps brachii muscle
- Lateral head of triceps brachii muscle
- Medial head of triceps brachii muscle
- Posterior cutaneous nerve of arm
- Medial cutaneous nerve of forearm
- Long head of biceps tendon
- Short head of the biceps brachii tendon
- Deltoid Tendon (Proximal)
- Deltoid tendon (Distal)
- Teres major tendon (Distal)
- Teres minor tendon (Distal)
- Latissimus dorsi tendon
- Subscapularis tendon
- Infraspinatus tendon
- Supraspinatus tendon
- Glenohumeral ligaments
- Superior glenohumeral ligament
- Middle glenohumeral ligament
- Inferior glenohumeral ligament
- Inferior glenohumeral ligament anterior band
- Inferior glenohumeral ligament posterior band
- Inferior glenohumeral ligament, axillary pouch
- Coracohumeral ligament
- Coracoacromial ligament
- Coracoclavicular Ligaments
- Conoid ligament
- Trapezoid ligament
- Acromioclavicular ligament
- Inferior acromioclavicular ligament
- Superior acromioclavicular ligament
- Glenohumeral joint capsule
- Glenoid labrum
- Shoulder joint (glenohumeral joint)
- Acromioclavicular joint
- Articular cartilage of glenoid fossa
- Adipose tissue (Shoulder)
- Subacromial space
- Supraclavicular fossa
- Radial artery
- Ulnar artery
- Anterior ulnar recurrent artery
- Posterior ulnar recurrent artery
- Recurrent interosseous artery
- Inferior ulnar collateral artery
- Superior ulnar collateral artery
- Radial recurrent artery
- Radial collateral artery
- Middle collateral artery
- Cephalic vein of forearm
- Accessory cephalic vein
- Basilic vein
- Median cubital vein
- Accessory median cubital vein
- Median antebrachial vein
- Radial veins
- Ulnar veins
- Anterior interosseous veins
- Posterior interosseous veins
- Posterior interosseous artery
- Anterior interosseous artery
- Flexor carpi radialis muscle
- Palmaris longus muscle
- Flexor carpi ulnaris muscle
- Flexor carpi ulnaris muscle (humeral head)
- Flexor carpi ulnaris (ulnar head)
- Flexor digitorum superficialis muscle
- Flexor digitorum superficialis muscle (humeroulnar head)
- Flexor digitorum superficialis muscle (radial head)
- Flexor digitorum profundus muscle
- Pronator teres muscle
- Pronator teres muscle (humeral head)
- Pronator teres muscle (ulnar head)
- Brachialis muscle
- Brachioradialis muscle
- Extensor carpi radialis longus muscle
- Extensor carpi radialis brevis muscle
- Extensor digitorum muscle
- Extensor digiti minimi muscle
- Extensor carpi ulnaris muscle
- Extensor carpi ulnaris muscle (Humeral Head)
- Anconeus muscle
- Supinator muscle
- Articularis cubiti muscle
- Radial nerve (deep branch)
- Radial nerve (superficial branch)
- Musculocutaneous nerve
- Lateral cutaneous nerve of forearm
- Medial cutaneous nerve of forearm (anterior branch)
- Medial cutaneous nerve of forearm (posterior branch)
- Inferior lateral cutaneous nerve of arm
- Posterior cutaneous nerve of forearm
- Radius
- Ulna
- Medial epicondyle of humerus
- Lateral epicondyle of humerus
- Olecranon fossa
- Capitulum of humerus
- Trochlea of humerus
- Lateral supracondylar ridge
- Medial supracondylar ridge
- Olecranon
- Coronoid process of ulna
- Head of radius
- Neck of radius
- Body of radius
- Radial tuberosity
- Radial notch of ulna
- Trochlear notch of ulna
- Coronoid fossa
- Humeroulnar joint
- Humeroradial joint
- Proximal radioulnar joint
- Elbow joint
- Biceps brachii tendon (distal)
- Triceps brachii tendon
- Common extensor tendon
- Common flexor tendon
- Bicipital aponeurosis
- Brachial fascia
- Antebrachial fascia
- Joint capsule of elbow
- Annular ligament of radius
- Radial collateral ligament
- Lateral ulnar collateral ligament
- Lateral collateral ligament complex of elbow
- Medial collateral ligament of elbow (anterior bundle)
- Medial collateral ligament of elbow (posterior bundle)
- Medial collateral ligament of elbow (transverse bundle)
- Medial collateral ligament complex of elbow (ulnar collateral ligament)
- Quadrate ligament
- Oblique cord (ligament of Weitbrecht)
- Osborne’s ligament (cubital tunnel retinaculum)
- Cubital tunnel
- Medial intermuscular septum
- Lateral intermuscular septum
- Supratrochlear lymph nodes
- Anterior fat pad of elbow joint
- Posterior fat pad of elbow joint
- Deltoid tuberosity
- Spiral glenohumeral ligament
- Superior transverse scapular ligament
- Inferior transverse scapular ligament
- Biceps pulley
- Third metacarpal styloid process
- Dorsal radial tubercle (Lister’s tubercle)
- Radial styloid process
- Ulnar styloid process
- Body of metacarpal bone
- Head of metacarpal bone
- Base of metacarpal bone
- Carpal bones
- Metacarpal bones
- Midcarpal joint
- Radiocarpal joint (wrist joint)
- Carpometacarpal joints
- Carpal articular surface
- Scaphoid
- Lunate
- Triquetrum
- Pisiform
- Trapezium
- Trapezoid
- Tubercle of trapezium bone
- Capitate
- Hamate
- Hook of hamate bone
- Distal radioulnar joint
- First metacarpal bone (metacarpal I)
- Second metacarpal bone (metacarpal II)
- Third metacarpal bone (metacarpal III)
- Fourth metacarpal bone (metacarpal IV)
- Fifth metacarpal bone (metacarpal V)
- Head of ulna
- Tubercle of the scaphoid bone
- Abductor pollicis brevis muscle
- Flexor pollicis brevis muscle
- Flexor pollicis brevis muscle (Superficial head)
- Flexor pollicis brevis muscle (Deep head)
- Adductor pollicis muscle
- Adductor pollicis muscle (Transverse head)
- Adductor pollicis muscle (Oblique head)
- Opponens pollicis muscle
- Abductor digiti minimi muscle (hand)
- Flexor digiti minimi brevis muscle (hand)
- Opponens digiti minimi muscle (hand)
- Palmaris brevis muscle
- First dorsal interosseous muscle of hand
- Second dorsal interosseous of hand
- Third dorsal interosseous muscle of hand
- Fourth dorsal interosseous muscle of hand
- First plantar interosseous muscle of hand
- Second plantar interosseous muscle of hand
- Third plantar interosseous muscle of hand
- First lumbrical muscle of hand
- Second lumbrical muscle of hand
- Third lumbrical muscle of hand
- Fourth lumbrical muscle of hand
- Flexor pollicis longus muscle
- Pronator quadratus muscle
- Extensor pollicis longus muscle
- Extensor pollicis brevis muscle
- Abductor pollicis longus muscle
- Extensor indicis muscle
- Flexor pollicis longus tendon
- Palmaris longus tendon
- Flexor carpi radialis tendon
- Flexor carpi ulnaris tendon
- Flexor digitorum profundus tendons
- Flexor digitorum superficialis tendons
- First flexor digitorum profundus tendon
- Second flexor digitorum profundus tendon
- Third flexor digitorum profundus tendon
- Fourth flexor digitorum profundus tendon
- First flexor digitorum superficialis tendon
- Second flexor digitorum superficialis tendon
- Third flexor digitorum superficialis tendon
- Fourth flexor digitorum superficialis tendon
- Extensor carpi radialis longus tendon
- Extensor carpi radialis brevis tendon
- Extensor carpi ulnaris tendon
- Extensor digitorum tendons
- Extensor indicis tendon
- Extensor digiti minimi tendon
- Extensor pollicis longus tendon
- Extensor pollicis brevis tendon
- Abductor pollicis longus tendon
- Brachioradialis tendon
- First extensor digitorum tendon (Extensor digitorum tendon to index finger)
- Second extensor digitorum tendon (Extensor digitorum tendon to middle finger)
- Third extensor digitorum tendon (Extensor digitorum tendon to ring finger)
- Fourth extensor digitorum tendon (Extensor digitorum tendon to little finger)
- Carpal tunnel region
- Dorsal radiocarpal ligament
- Volar radioulnar ligament
- Dorsal radioulnar ligament
- Short radiolunate ligament
- Long radiolunate ligament
- Volar radioscaphocapitate ligament
- Volar scapholunate ligament
- Dorsal scapholunate ligament
- Interosseous scapholunate ligament
- Volar lunotriquetral ligament
- Dorsal lunotriquetral ligament
- Ulnotriquetral ligament
- Volar ulnolunate ligament
- Dorsal ulnolunate ligament
- Ulnocapitate ligament
- Ulnocarpal ligaments
- Pisohamate ligament
- Pisometacarpal ligament
- Ulnar collateral ligament of wrist
- Radial collateral ligament of wrist
- Dorsal intercarpal ligaments
- Capitotrapezoid ligament (Trapezocapitate ligament)
- Dorsal capitotrapezoid ligament (Trapezocapitate ligament)
- Palmar capitotrapezoid ligament (Trapezocapitate ligament)
- Trapeziotrapezoid ligament
- Dorsal trapeziotrapezoid ligament
- Palmar trapeziotrapezoid ligament
- Capitohamate ligament
- Volar capitohamate ligament
- Dorsal capitohamate ligament
- Dorsal deltoid ligament
- Anterior oblique ligament (beak ligament)
- Flexor retinaculum of wrist
- Extensor retinaculum of wrist
- Palmar aponeurosis
- Triangular fibrocartilage complex (TFCC )
- Triangular fibrocartilage disc
- Radialis indicis artery
- Princeps pollicis artery
- Dorsal carpal branch of radial artery
- Superficial palmar arch
- Deep palmar arch
- Palmar branch of cephalic vein
- Perforating branches of ulnar veins
- Dorsal venous network of hand
- Deep venous palmar arch
- Deep branch of ulnar nerve
- Dorsal digital branches of radial nerve
- Dorsal digital branch of ulnar nerve
- Common palmar digital branch of ulnar nerve
- Common palmar digital nerves of median nerve
- Proper palmar digital nerves
- Guyon’s canal
- Phalanx bone (hand)
- Proximal phalanx of hand
- Middle phalanx of hand
- Distal phalanx of hand
- Head of the phalanx (hand)
- Base of the phalanx (hand)
- Body of the phalanx (hand)
- Second dorsal interosseous muscle of hand
- Dorsal interosseous muscle of hand
- Palmar interosseous muscles of hand
- Metacarpophalangeal joints
- Proximal interphalangeal joints of hand
- Distal interphalangeal joint of hand
- Tuberosity of distal phalanx
- Olfactory trigone
- Olfactory tubercle
- Ophthalmic nerve
- Lesser wing of sphenoid
- Anterior clinoid process
- Sphenoparietal sinus
- Carotid siphon
- Scala vestibuli
- Scala media
- Scala tympani
- Interscalar septum
- Spiral canal of cochlea
- Cochlear duct
- Utricle
- Saccule
- Posterior semicircular canal
- Lateral semicircular canal
- Anterior semicircular canal
- Posterior bony ampulla
- Common bony crus
- Mastoid air cells
- Cochlear Canaliculus
- Inferior vestibular nerve
- Superior vestibular nerve
- Tympanic segment of facial nerve
- Temporal lobe
- Anterior bony ampulla
- Apex of insula
- Insular lobe
- Genioglossus muscle
- Nasal bones
- Ascending pharyngeal artery
- Medial atlantoaxial joint
- Pharyngeal tonsil
- Frontal bone
- Hard palate
- Frontal sinus
- Ethmoid sinus
- Ethmoidal air cells
- Sphenoid sinus
- Middle Nasal Meatus
- Inferior nasal meatus
- Superior nasal meatus
- Central axillary lymph nodes
- Right lung
- Left lung
- Retrosternal space
- Manubriosternal joint
- Jugular notch
- Clavicular notch
- Sternal angle
- Anterior sternoclavicular ligament
- Xiphisternal joint
- Radiate sternocostal ligament
- Jugular tubercle
- Intervertebral foramen
- Groove for vertebral artery
- Apical ligament of dens
- Superior pharyngeal constrictor muscle
- Middle pharyngeal constrictor muscle
- Inferior pharyngeal constrictor muscle
- Periaortic lymph nodes
- Middle Colic Vein
- Posterior cecal artery
- Ampulla of vas deferens
- Deep dorsal vein of penis
- Internal pudendal artery
- Internal pudendal vein
- Ureteric Orifice
- Lateral fornix of cervix
- Posterior fornix of cervix
- Anterior fornix of cervix
- Posterior glenoid labrum
- Anterior glenoid labrum
- Transverse humeral ligament
- Deep brachial artery
- Articular facet of head of radius
- Cubital anastomosis
- Nail (hand)
- Nail bed (hand)
- Nail bed corion (hand)
- Lateral nail fold (hand)
- Adipose tissue (hand)
- Dermis of skin (hand)
- Epidermis of skin (hand)
- Volar plate (hand)
- Interosseous lateral band
- Flexor tendon synovial sheath
- Central slip of common extensor tendon
- Dorsal interossei tendon hand
- Palmar Interossei Tendon hand
- Dorsal digital nerve (hand)
- Proper palmar digital nerve (hand)
- Proper palmar digital arteries (hand)
- Proper palmar digital veins (hand)
- Dorsal digital veins (hand)
- Dorsal digital arteries (hand)
- Dorsal capsule of the metacarpophalangeal joint
- Proper collateral ligament
- Accessory collateral ligament
- Annular ligament (annular pulley)
- Head of distal phalanx
- Base of distal phalanx
- Intermediate phalanx
- Head of proximal phalanx
- Body of proximal phalanx
- Base of proximal phalanx
- Acetabular notch
- Trochanteric fossa
- Posterior wall of acetabulum
- Anterior wall of acetabulum
- Gluteal tuberosity
- Third trochanter
- Intertrochanteric crest
- Crista galli
- Lacrimal bone
- Septum of sphenoid sinus
- Eyeball
- Vertebral artery
- Right coronary aortic sinus
- Left coronary aortic sinus
- Straight Arteries
- Right branch of portal vein
- Left branch of portal vein
- Anterior right branch of portal vein
- Posterior right branch of portal vein
- Annular ligaments (annular pulleys)
- Basilar part of pons
- Basilar venous plexus
- Cerebellar falx
- Inferior hemispheric cerebellar veins
- Lateral part of biventeral lobule
- Medial part of biventeral lobule
- Medullopontine sulcus
- Peduncle of flocculus
- Pontomedullary junction
- Preolivary groove
- Pyramid of medulla oblongata
- Retroolivary groove
- White substance of cerebellum
- Pontine artery
- Anterolateral pontine vein
- Superior hemispheric cerebellar veins
- Crus cerebri
- Tegmentum of pons
- Superior cerebellar peduncle
- Posterior quadrangular lobule
- Vermis of cerebellum
- Amygdalohippocampal area
- Infundibulum
- Anterior calcarine sulcus
- Rostral gyrus
- Rostral sulcus
- Orbital Sulci
- Orbital gyri
- Paraolfactory sulci
- Posterior orbital sulcus
- Transverse occipital sulcus
- Transverse temporal sulcus
- Hypothalamus
- Extreme capsule
- foramen of Monro
- Cerebral falx
- Meninges
- Frontobasal artery
- Inferior parietal lobule
- Body of lateral ventricle
- Perivascular spaces
- Paracentral lobule
- Paracentral gyrus
- Marginal branch of cingulate sulcus
- Sagittal suture
- Posterior median sulcus of medulla oblongata
- Pons (basilar portion)
- Medial lemniscus
- Spinothalamic tract
- Gracile fasciculus
- Cuneate fasciculus
- Hypoglossal nucleus
- Dorsal nucleus of vagus nerve
- Nucleus of the solitary tract
- Spinal trigeminal nucleus (pars caudalis)
- Spinal trigeminal nucleus (pars oralis)
- Spinal trigeminal nucleus
- Ventral cochlear nucleus
- Dorsal cochlear nucleus
- Nucleus supraspinalis
- Pontocerebellar fibers
- Parabrachial recess
- Lateral lemniscus
- Spinal lemniscus
- Fibers of trigeminal nerve
- Principal sensory nucleus of trigeminal nerve
- Locus ceruleus
- Nucleus reticularis tegmenti pontis
- Pes hippocampi
- Hypophysial cistern
- Amygdaloclaustral area
- Lateral pallidum
- Medial pallidum
- Caudatolenticular gray bridges
- Hypothalamic sulcus
- Lateral groove of midbrain
- Tectal plate
- Precommunicating part of posterior cerebral artery
- Calcarine branch of posterior cerebral artery
- Tenia of fornix
- Stria medullaris thalami
- Habenula
- Tela choroidea of third ventricle
- Choroid plexus of the lateral ventricle
- Medial vein of lateral ventricle
- Vertex
- Coronal suture
- Lambdoid suture
- Frontal suture
- Parietal bone
- Temporal bone
- Nasal bone
- Maxillary bone
- Zygomatic process of frontal bone
- Frontal process of zygomatic bone
- Petrous ridge
- Orbital cavity
- Medial wall of orbit
- Lateral wall of the orbit
- Supraorbital margin
- Infraorbital margin
- Sphenoidal sinus
- Lateral wall of maxillary sinus
- Medial wall of maxillary sinus
- Inferior wall of maxillary sinus
- Superior wall of the maxillary sinus
- Bony nasal septum
- Perpendicular plate
- Cribriform plate
- Nasal crest of maxilla
- Teeth
- Angle of mandible
- Coronoid process of mandible
- Superciliary arch
- Innominate line (skull)
- Internal occipital crest
- Odontoid process
- Nasal part of frontal bone
- Frontonasal suture
- Anterior ethmoidal air cells
- Nasal spine of frontal bone
- Alveolar arch of maxilla
- Cartilaginous part of nasal septum
- Lateral nasal cartilage
- Major alar cartilage
- Minor alar cartilage
- Apex of nose
- Apex of right lung
- Apex of left lung
- Superior lobe of right lung
- Superior lobe of left lung
- Middle lobe of right lung
- Inferior lobe of right lung
- Inferior lobe of left lung
- Base of right lung
- Hilum of lung
- Aortic knob
- Mediastinum
- Right paratracheal stripe
- Left paratracheal stripe
- Right paraspinal line
- Left paraspinal line
- Paraaortic line
- Azygoesophageal line
- Right cardiophrenic angle
- Left cardiophrenic angle
- Right costophrenic angle
- Left costophrenic angle
- Glenohumeral joint
- Head of rib
- Neck of rib
- Body of rib
- Anterior ribs
- Posterior ribs
- Intercostal space
- Gastric bubble
- Breast shadow
- Axilla
- C1 Vertebra (Atlas)
- C2 Vertebra (Axis)
- Zygapophyseal joint
- Uncinate process of vertebra
- Intervertebral disc space
- Aortic arch
- Annular epiphysis
- Sacrococcygeal joint
- Iliac bone
- Iliac fossa
- L (Lumbar spine)
- S (Sacral spine)
- Co (Coccyx)
- T (Thoracic spine)
- C (Cervical spine)
- Fovea for ligament of head of femur
- Obturator foramen
- Transverse abdominal muscle
- Superior articular process of sacrum
- Penis
- Hamstring muscles
- Shenton’s line
- Iliopectineal line
- Ilioischial line
- Adductor tubercle
- Intercondylar fossa
- Articular surface of medial femoral condyle
- Articular surface of lateral femoral condyle
- Groove for popliteus muscle
- Medial condyle of tibia
- Lateral condyle of tibia
- Intercondylar eminence
- Articular surface of medial tibial condyle
- Articular surface of lateral tibial condyle
- Fibular articular facet of tibia
- Body of fibula
- Apex of head of fibula
- Articular facet of head of fibula
- Lateral tibiofemoral joint space
- Medial tibiofemoral joint space
- Tubercle of iliotibial tract
- Lateral supracondylar line
- Medial supracondylar line
- Superior rim of acetabulum
- Anterior rim of acetabulum
- Posterior rim of acetabulum
- Inferior rim of acetabulum
- Inferior articular surface of tibia
- Fibular notch of tibia
- Inferior tibiofibular joint
- Posterior malleolus
- Apex of medial malleolus
- Apex of lateral malleolus
- Articular facet of lateral malleolus
- Articular facet of medial malleolus
- Anterior colliculus of medial malleolus
- Posterior colliculus of medial malleolus
- Malleolar fossa
- Trochlea of talus
- Superior facet of talus
- Medial malleolar facet of talus
- Lateral malleolar facet of talus
- Calcaneal tuberosity
- Medial process of calcaneal tuberosity
- Lateral process of calcaneal tuberosity
- Calcaneal tubercle
- Subtalar joint
- Talonavicular joint
- First intercuneiform joint
- Second intercuneiform joint
- Tuberosity of fifth metatarsal bone
- Metatarsal Bones (MT)
- Kager’s fat pad
- Tuberosity of cuboid bone
- Tarsal sinus
- Articular surface for cuboid bone
- Tuberosity of distal phalanx of foot
- Trochlea of phalanx
- Metatarsophalangeal joint of great toe
- Interphalangeal sesamoid of great toe
- Tuberosity of first metatarsal bone
- Intermetatarsal joints
- Lisfranc complex
- Navicular articular surface
- Cuboid articular surface
- Body of distal phalanx of great toe
- Head of distal phalanx of great toe
- Base of distal phalanx of great toe
- Tuberosity of distal phalanx of great toe
- Trochlea of phalanx of great toe
- Base of proximal phalanx of great toe
- Body of proximal phalanx of great toe
- Head of proximal phalanx of great toe
- Head of first metatarsal bone
- Body of first metatarsal bone
- Base of first metatarsal bone
- Second tarsometatarsal joint
- First tarsometatarsal joint
- Posterior talar articular surface
- Middle talar articular surface
- Fibular trochlea
- Anterior talar articular surface
- Lateral tubercle of talus
- Posterior calcaneal articular facet
- Soleal line
- Superior tibiofibular joint
- Posterior process
- Medial tubercle of talus
- Lateral process of talus
- Tibiofemoral joint space
- Trapezoid Line
- Superior border of scapula
- Medial border of scapula
- Lateral border of scapula
- Superior angle of scapula
- Inferior angle of scapula
- Anterior rim of glenoid
- Posterior rim of glenoid
- Supraglenoid tubercle
- Infraglenoid tubercle
- Crest of greater tubercle
- Crest of lesser tubercle
- Radial fossa
- Tuberosity of ulna
- Body of ulna
- Lateral border of humerus
- Medial border of humerus
- Metacarpophalangeal joint of thumb
- Ulnar sesamoid bone of thumb
- Radial sesamoid bone of thumb
- Intermetacarpal joints
- Carpometacarpal joint of thumb
- Tubercle of scaphoid
- Interosseous border
- Body of distal phalanx
- Head of middle phalanx
- Body of middle phalanx
- Base of the middle phalanx
- Interphalangeal joint of thumb
- Base of middle phalanx
- Sesamoid bone of interphalangeal joint
- Proximal phalanx of thumb
- Metacarpal bone of thumb
- Posterior clinoid process
- Pituitary fossa
- Soft palate
- Posterior nasal spine
- Posterior part of tongue
- Superior wall of orbit
- Glabella
- Frontal process of maxilla
- Mental protuberance
- Mandibular notch
- Posterior border of maxilla
- Incisive foramen
- Floor of the maxillary sinus
- Medial wall of the maxillary sinus
- Pterygomaxillary fissure
- Floor of orbit
- Infraorbital canal
- Nasal cavity
- Apical foramen
- Periodontal ligament
- Cementum
- Dental pulp
- Cementoenamel junction
- Dentine
- Enamel
- Tibial shaft

The posterior segmental bronchus of the right lung (B2) is one of the three segmental bronchi arising from the right upper lobar bronchus (secondary bronchus). It specifically supplies the posterior segment (S2) of the right upper lobe.
Anatomically, B2 branches posteriorly and laterally from the right upper lobar bronchus, passing toward the posterior part of the upper lobe, accompanying its corresponding pulmonary artery branch (A2) and vein (V2). Together, these structures define the bronchopulmonary segment.
The posterior segment is wedge-shaped and oriented posteriorly, making it an important landmark in bronchoscopic navigation, thoracic surgery, and radiological segmental analysis. Precise knowledge of B2 anatomy is essential for segmentectomy, lung cancer surgery, and interventional bronchoscopy.
Synonyms
-
Right upper lobe posterior segmental bronchus
-
B2 bronchus
-
Bronchus to segment S2 of right lung
Function
-
Conducts air to and from the posterior segment (S2) of the right upper lobe
-
Works with segmental arteries (A2) and veins (V2) to form the bronchopulmonary segment
-
Key structure for ventilation, gas exchange, and bronchoscopic orientation
Branches
-
Subsegmental bronchi (B2a, B2b ± B2c depending on variation)
-
Supply different subregions of the posterior segment (S2)
-
MRI Appearance
T1-weighted images:
-
Bronchial lumen appears as a signal void (black) when aerated
-
Walls show low to intermediate signal
T2-weighted images:
-
Aerated lumen remains hypointense (signal void)
-
Surrounding parenchyma is hyperintense in cases of consolidation or edema
STIR:
-
Suppresses surrounding fat, highlighting peribronchial pathology such as inflammation, edema, or tumor spread
T1 Post-Gadolinium (Gd-enhanced MRI):
-
Normal bronchial lumen does not enhance
-
Peribronchial soft tissues and pathological wall thickening show enhancement, useful in evaluating bronchial tumors or inflammatory disease
MRI Non-Contrast Cardiac/Respiratory-Gated 3D Imaging:
-
Provides 3D mapping of segmental bronchial tree including B2
-
Useful for pre-surgical planning and virtual bronchoscopy
CT Appearance
CT (High-resolution CT / HRCT):
-
Best modality to visualize B2 and its subsegmental branches
-
Lumen seen as an air-filled tubular structure with thin walls in the posterior upper lobe
-
Multiplanar reconstructions show relation to pulmonary vessels and intersegmental planes
CT Post-Contrast (CT Pulmonary Angiography / CT Bronchography):
-
Enhances surrounding vessels (A2, V2) and peribronchial tissues
-
Useful in evaluating bronchovascular relationships, compression, or invasion by tumors
-
Critical for surgical planning in segmentectomy and lobectomy
CT image